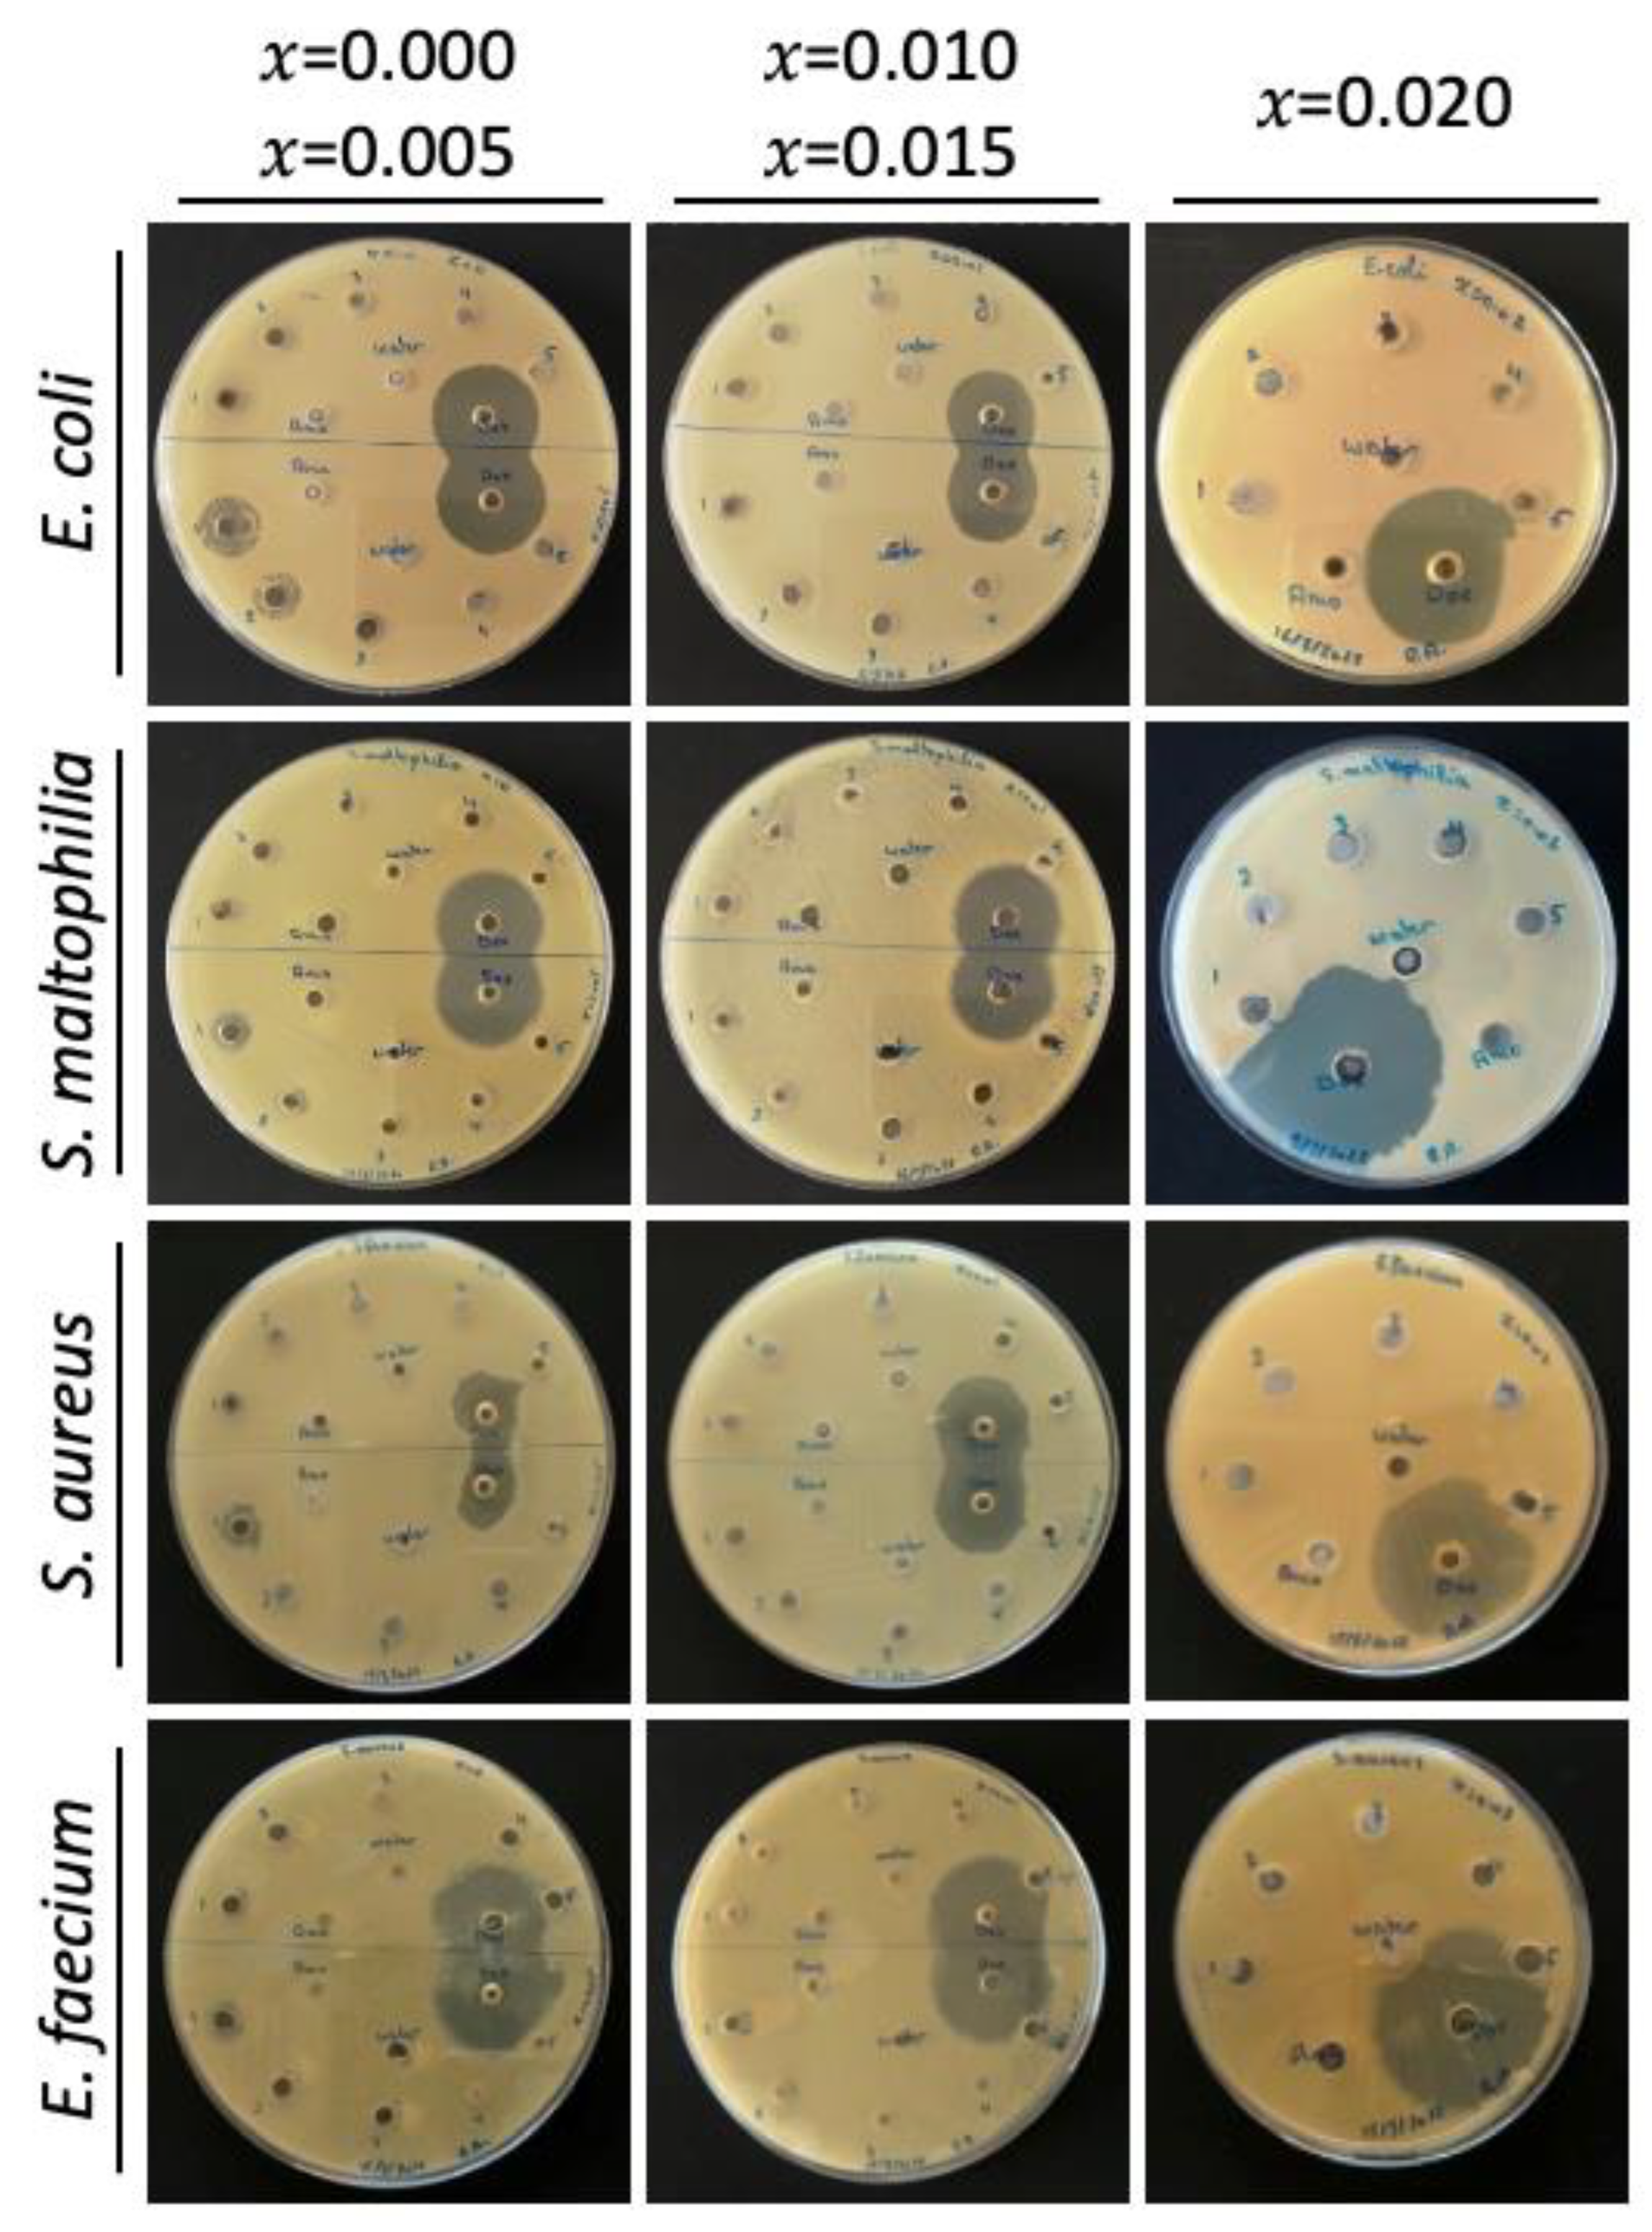
Molecules 28 00103 g0a4 Molecules 28 00103 g0a4

Synthesis, Characterization, and Antibacterial Activity of Mg-Doped CuO Nanoparticles
Abstract
1. Introduction
2. Results
2.1. Characterization of NPs
2.1.1. X-ray Diffraction
2.1.2. Transmission Electron Microscope
2.1.3. Scanning Electron Microscope and Energy Dispersive X-ray
2.1.4. Fourier Transform Infrared (FTIR)
2.1.5. Photoluminescence (PL)
2.2. Antibacterial Activity of the Undoped and Mg-Doped CuO NPs
2.2.1. MIC and MBC
2.2.2. Agar Well Diffusion
2.2.3. Time-Kill Results
3. Discussion
4. Materials and Methods
4.1. Synthesis of NPs
4.2. Characterization of Mg-Doped CuO NPs
4.3. Isolation of Bacteria
4.4. Broth Microdilution Assay: Minimum Inhibitory Concentration (MIC) and Minimum Bactericidal Concentration (MBC)
4.5. Agar Well Diffusion Assay
4.6. Time-Kill Test
4.7. Statistical Analysis
5. Conclusions
Author Contributions
Funding
Institutional Review Board Statement
Informed Consent Statement
Data Availability Statement
Conflicts of Interest
Appendix A

| Nanoparticles | Bacterial Isolates | ||||||||
|---|---|---|---|---|---|---|---|---|---|
| Gram-Positive Bacteria | Gram-Negative Bacteria | ||||||||
| S. aureus | Significance | E. faecium | Significance | E. coli | Significance | S. maltophilia | Significance | ||
| S | (mg/mL) | p-values (vs. Dox) | |||||||
| x = 0.000 | 0.1875 | 0.005 | ** | 0.003 | ** | ˂0.001 | *** | ˂0.001 | *** |
| 0.375 | 0.005 | ** | 0.006 | ** | ˂0.001 | *** | ˂0.001 | *** | |
| 0.75 | 0.005 | ** | 0.004 | ** | ˂0.001 | *** | ˂0.001 | *** | |
| 1.5 | 0.01 | ** | 0.010 | ** | 0.01 | ** | 0.001 | *** | |
| 3 | 0.007 | ** | 0.007 | ** | 0.02 | * | ˂0.001 | *** | |
| x = 0.005 | 0.1875 | 0.001 | *** | 0.005 | ** | ˂0.001 | *** | ˂0.001 | *** |
| 0.375 | 0.001 | *** | 0.005 | ** | ˂0.001 | *** | ˂0.001 | *** | |
| 0.75 | 0.001 | *** | 0.005 | ** | ˂0.001 | *** | ˂0.001 | *** | |
| 1.5 | ˂0.001 | *** | 0.010 | ** | 0.002 | ** | ˂0.001 | *** | |
| 3 | ˂0.001 | *** | 0.006 | ** | 0.001 | *** | 0.001 | *** | |
| x = 0.010 | 0.1875 | 0.001 | *** | 0.005 | ** | ˂0.001 | *** | ˂0.001 | *** |
| 0.375 | 0.001 | *** | 0.005 | ** | ˂0.001 | *** | ˂0.001 | *** | |
| 0.75 | 0.001 | *** | 0.005 | ** | 0.030 | * | ˂0.001 | *** | |
| 1.5 | 0.001 | *** | 0.010 | ** | 0.040 | * | ˂0.001 | *** | |
| 3 | 0.002 | ** | 0.020 | * | 0.002 | ** | ˂0.001 | *** | |
| x = 0.015 | 0.1875 | 0.001 | *** | 0.003 | ** | ˂0.001 | *** | ˂0.001 | *** |
| 0.375 | 0.001 | *** | 0.003 | ** | ˂0.001 | *** | ˂0.001 | *** | |
| 0.75 | 0.002 | ** | 0.003 | ** | ˂0.001 | *** | ˂0.001 | *** | |
| 1.5 | ˂0.001 | *** | 0.003 | ** | 0.003 | ** | ˂0.001 | *** | |
| 3 | 0.001 | *** | 0.003 | ** | 0.006 | ** | 0.001 | *** | |
| x = 0.020 | 0.1875 | ˂0.001 | *** | 0.002 | ** | ˂0.001 | *** | ˂0.001 | *** |
| 0.375 | ˂0.001 | *** | 0.002 | ** | ˂0.001 | *** | ˂0.001 | *** | |
| 0.75 | ˂0.001 | *** | 0.002 | ** | ˂0.001 | *** | ˂0.001 | *** | |
| 1.5 | ˂0.001 | *** | 0.002 | ** | ˂0.001 | *** | ˂0.001 | *** | |
| 3 | 0.002 | ** | 0.02 | * | 0.001 | *** | ˂0.001 | *** | |
References
- Chandrappa, K.G.; Venkatesha, T.V. Generation of Nanostructured CuO by Electrochemical Method and Its Zn–Ni–CuO Composite Thin Films for Corrosion Protection. Mater. Corros. 2013, 64, 831–839. [Google Scholar] [CrossRef]
- Surendhiran, S.; Gowthambabu, V.; Balamurugan, A.; Sudha, M.; Senthil Kumar, V.B.; Suresh, K.C. Rapid Green Synthesis of CuO Nanoparticles and Evaluation of Its Photocatalytic and Electrochemical Corrosion Inhibition Performance. Mater. Today Proc. 2021, 47, 1011–1016. [Google Scholar] [CrossRef]
- Butte, S.M.; Waghuley, S.A. Optical Properties of Cu2O and CuO. AIP Conf. Proc. 2020, 2220, 020093. [Google Scholar] [CrossRef]
- Koshy, J.; Samuel, M.S.; Chandran, A.; George, K.C. Optical Properties of CuO Nanoparticles. AIP Conf. Proc. 2011, 1391, 576–578. [Google Scholar] [CrossRef]
- Arun, K.; Batra, A.; Krishna, A.; Bhat, K.; Aggarwal, M.; Francis, J. Surfactant Free Hydrothermal Synthesis of Copper Oxide Nanoparticles. Am. J. Mater. Sci. 2015, 2015, 36–38. [Google Scholar] [CrossRef]
- Singh, S.; Goswami, N.; Mohapatra, S.R.; Singh, A.K.; Kaushik, S.D. Significant Magnetic, Dielectric and Magnetodielectric Properties of CuO Nanoparticles Prepared by Exploding Wire Technique. Mater. Sci. Eng. B 2021, 271, 115301. [Google Scholar] [CrossRef]
- Lv, Y.; Li, L.; Yin, P.; Lei, T. Synthesis and Evaluation of the Structural and Antibacterial Properties of Doped Copper Oxide. Dalton Trans. 2020, 49, 4699–4709. [Google Scholar] [CrossRef]
- Khalid, A.; Ahmad, P.; Alharthi, A.I.; Muhammad, S.; Khandaker, M.U.; Rehman, M.; Faruque, M.R.I.; Din, I.U.; Alotaibi, M.A.; Alzimami, K.; et al. Structural, Optical, and Antibacterial Efficacy of Pure and Zinc-Doped Copper Oxide Against Pathogenic Bacteria. Nanomaterials 2021, 11, 451. [Google Scholar] [CrossRef]
- Raba-Páez, A.M.; Malafatti, J.O.D.; Parra-Vargas, C.A.; Paris, E.C.; Rincón-Joya, M. Effect of Tungsten Doping on the Structural, Morphological and Bactericidal Properties of Nanostructured CuO. PLoS ONE 2020, 15, e0239868. [Google Scholar] [CrossRef]
- Ahamed, M.; Alhadlaq, H.A.; Khan, M.A.M.; Karuppiah, P.; Al-Dhabi, N.A. Synthesis, Characterization, and Antimicrobial Activity of Copper Oxide Nanoparticles. J. Nanomater. 2014, 2014, 17. [Google Scholar] [CrossRef]
- Jayaprakash, J.; Srinivasan, N.; Chandrasekaran, P. Surface Modifications of CuO Nanoparticles Using Ethylene Diamine Tetra Acetic Acid as a Capping Agent by Sol–Gel Routine. Spectrochim. Acta. A. Mol. Biomol. Spectrosc. 2014, 123, 363–368. [Google Scholar] [CrossRef] [PubMed]
- Raveesha, H.R.; Sudhakar, M.S.; Pratibha, S.; Ravikumara, C.R.; Nagaswarupa, H.P.; Dhananjaya, N. Costus Pictus Leaf Extract Mediated Biosynthesis of Fe and Mg Doped CuO Nanoparticles: Structural, Electrochemical and Antibacterial Analysis. Mater. Res. Express 2019, 6, 1150.e5. [Google Scholar] [CrossRef]
- Din, S.U.; Sajid, M.; Imran, M.; Iqbal, J.; Shah, B.A.; Shah, S. One Step Facile Synthesis, Characterization and Antimicrobial Properties of Mg-Doped CuO Nanostructures. Mater. Res. Express 2019, 6, 085022. [Google Scholar] [CrossRef]
- Scimeca, M.; Bischetti, S.; Lamsira, H.K.; Bonfiglio, R.; Bonanno, E. Energy Dispersive X-Ray (EDX) Microanalysis: A Powerful Tool in Biomedical Research and Diagnosis. Eur. J. Histochem. EJH 2018, 62, 2841. [Google Scholar] [CrossRef] [PubMed]
- Pramothkumar, A.; Senthilkumar, N.; Mercy Gnana Malar, K.C.; Meena, M.; Vetha Potheher, I. A Comparative Analysis on the Dye Degradation Efficiency of Pure, Co, Ni and Mn-Doped CuO Nanoparticles. J. Mater. Sci. Mater. Electron. 2019, 30, 19043–19059. [Google Scholar] [CrossRef]
- Singh, H.; Yadav, K.L. Structural, Dielectric, Vibrational and Magnetic Properties of Sm Doped BiFeO3 Multiferroic Ceramics Prepared by a Rapid Liquid Phase Sintering Method. Ceram. Int. 2015, 41, 9285–9295. [Google Scholar] [CrossRef]
- Singh, S.J.; Chinnamuthu, P. Highly Efficient Natural-Sunlight-Driven Photodegradation of Organic Dyes with Combustion Derived Ce-Doped CuO Nanoparticles. Colloids Surf. Physicochem. Eng. Asp. 2021, 625, 126864. [Google Scholar] [CrossRef]
- Siddiqui, H.; Parra, M.R.; Malik, M.M.; Haque, F.Z. Structural and Optical Properties of Li Substituted CuO Nanoparticles. Opt. Quantum Electron. 2018, 50, 260. [Google Scholar] [CrossRef]
- Siddiqui, H.; Parra, M.R.; Qureshi, M.S.; Malik, M.M.; Haque, F.Z. Studies of Structural, Optical, and Electrical Properties Associated with Defects in Sodium-Doped Copper Oxide (CuO/Na) Nanostructures. J. Mater. Sci. 2018, 53, 8826–8843. [Google Scholar] [CrossRef]
- Jamal, M.; Billah, M.M.; Ayon, S.A. Opto-Structural and Magnetic Properties of Fluorine Doped CuO Nanoparticles: An Experimental Study. Ceram. Int. 2022. [Google Scholar] [CrossRef]
- Dagher, L.A.; Hassan, J.; Kharroubi, S.; Jaafar, H.; Kassem, I.I. Nationwide Assessment of Water Quality in Rivers across Lebanon by Quantifying Fecal Indicators Densities and Profiling Antibiotic Resistance of Escherichia coli. Antibiotics 2021, 10, 883. [Google Scholar] [CrossRef] [PubMed]
- Singh, S.J.; Lim, Y.Y.; Hmar, J.J.L.; Chinnamuthu, P. Temperature Dependency on Ce-Doped CuO Nanoparticles: A Comparative Study via XRD Line Broadening Analysis. Appl. Phys. Mater. Sci. Process. 2022, 128, 188. [Google Scholar] [CrossRef]
- Gupta, D.; Meher, S.R.; Illyaskutty, N.; Alex, Z.C. Facile Synthesis of Cu2O and CuO Nanoparticles and Study of Their Structural, Optical and Electronic Properties. J. Alloys Compd. 2018, 743, 737–745. [Google Scholar] [CrossRef]
- Kumar, P.; Nene, A.G.; Punia, S.; Kumar, M.; Abbas, Z.; Thakral, F.; Tuli, H.S. SYNTHESIS, CHARACTERIZATION AND ANTIBACTERIAL ACTIVITY OF CUO NANOPARTICLES. Int. J. Appl. Pharm. 2020, 12, 17–20. [Google Scholar] [CrossRef]
- Kayani, Z.N.; Umer, M.; Riaz, S.; Naseem, S. Characterization of Copper Oxide Nanoparticles Fabricated by the Sol–Gel Method. J. Electron. Mater. 2015, 44, 3704–3709. [Google Scholar] [CrossRef]
- Muthukumaran, S.; Gopalakrishnan, R. Structural, FTIR and Photoluminescence Studies of Cu Doped ZnO Nanopowders by Co-Precipitation Method. Opt. Mater. 2012, 34, 1946–1953. [Google Scholar] [CrossRef]
- Wang, H.; Xu, J.-Z.; Zhu, J.-J.; Chen, H.-Y. Preparation of CuO Nanoparticles by Microwave Irradiation. J. Cryst. Growth 2002, 244, 88–94. [Google Scholar] [CrossRef]
- Chandrasekar, M.; Subash, M.; Logambal, S.; Udhayakumar, G.; Uthrakumar, R.; Inmozhi, C.; Al-Onazi, W.A.; Al-Mohaimeed, A.M.; Chen, T.-W.; Kanimozhi, K. Synthesis and Characterization Studies of Pure and Ni Doped CuO Nanoparticles by Hydrothermal Method. J. King Saud Univ. Sci. 2022, 34, 101831. [Google Scholar] [CrossRef]
- Siddiqui, H.; Parra, M.R.; Haque, F.Z. Optimization of Process Parameters and Its Effect on Structure and Morphology of CuO Nanoparticle Synthesized via the Sol−gel Technique. J. Sol-Gel Sci. Technol. 2018, 87, 125–135. [Google Scholar] [CrossRef]
- Abdallah, A.M.; Awad, R. Mixed Magnetic Behavior in Gadolinium and Ruthenium Co-Doped Nickel Oxide Nanoparticles. Phys. Scr. 2022, 97, 015802. [Google Scholar] [CrossRef]
- Jisr, N.; Younes, G.; El Omari, K.; Hamze, M.; Sukhn, C.; El-Dakdouki, M.H. Levels of Heavy Metals, Total Petroleum Hydrocarbons, and Microbial Load in Commercially Valuable Fish from the Marine Area of Tripoli, Lebanon. Environ. Monit. Assess. 2020, 192, 705. [Google Scholar] [CrossRef]
- Romanos, D.; Nemer, N.; Khairallah, Y.; Thérèse Abi Saab, M. Assessing the Quality of Sewage Sludge as an Agricultural Soil Amendment in Mediterranean Habitats. Int. J. Recycl. Org. Waste Agric. 2019, 8, 377–383. [Google Scholar] [CrossRef]
- Arenz, S.; Wilson, D.N. Bacterial Protein Synthesis as a Target for Antibiotic Inhibition. Cold Spring Harb. Perspect. Med. 2016, 6, a025361. [Google Scholar] [CrossRef] [PubMed]
- Speer, B.S.; Shoemaker, N.B.; Salyers, A.A. Bacterial Resistance to Tetracycline: Mechanisms, Transfer, and Clinical Significance. Clin. Microbiol. Rev. 1992, 5, 387–399. [Google Scholar] [CrossRef] [PubMed]
- Yoon, B.K.; Jackman, J.A.; Valle-González, E.R.; Cho, N.-J. Antibacterial Free Fatty Acids and Monoglycerides: Biological Activities, Experimental Testing, and Therapeutic Applications. Int. J. Mol. Sci. 2018, 19, 1114. [Google Scholar] [CrossRef] [PubMed]
- EL-Mekkawi, D.M.; Selim, M.M.; Hamdi, N.; Hassan, S.A.; Ezzat, A. Studies on the Influence of the Physicochemical Characteristics of Nanostructured Copper, Zinc and Magnesium Oxides on Their Antibacterial Activities. J. Environ. Chem. Eng. 2018, 6, 5608–5615. [Google Scholar] [CrossRef]
- Mersian, H.; Alizadeh, M.; Hadi, N. Synthesis of Zirconium Doped Copper Oxide (CuO) Nanoparticles by the Pechini Route and Investigation of Their Structural and Antibacterial Properties. Ceram. Int. 2018, 44, 20399–20408. [Google Scholar] [CrossRef]
- Moniri Javadhesari, S.; Alipour, S.; Mohammadnejad, S.; Akbarpour, M.R. Antibacterial Activity of Ultra-Small Copper Oxide (II) Nanoparticles Synthesized by Mechanochemical Processing against S. aureus and E. coli. Mater. Sci. Eng. C 2019, 105, 110011. [Google Scholar] [CrossRef]
- Rutgersson, C.; Ebmeyer, S.; Lassen, S.B.; Karkman, A.; Fick, J.; Kristiansson, E.; Brandt, K.K.; Flach, C.-F.; Larsson, D.G.J. Long-Term Application of Swedish Sewage Sludge on Farmland Does Not Cause Clear Changes in the Soil Bacterial Resistome. Environ. Int. 2020, 137, 105339. [Google Scholar] [CrossRef]
- Thakur, N.; Anu; Kumar, K.; Kumar, A. Effect of (Ag, Zn) Co-Doping on Structural, Optical and Bactericidal Properties of CuO Nanoparticles Synthesized by a Microwave-Assisted Method. Dalton Trans. 2021, 50, 6188–6203. [Google Scholar] [CrossRef]
- Dang, T.M.D.; Le, T.T.T.; Fribourg-Blanc, E.; Dang, M.C. Synthesis and Optical Properties of Copper Nanoparticles Prepared by a Chemical Reduction Method. Adv. Nat. Sci. Nanosci. Nanotechnol. 2011, 2, 015009. [Google Scholar] [CrossRef]
- Maruthapandi, M.; Saravanan, A.; Luong, J.H.T.; Gedanken, A. Antimicrobial Properties of Polyaniline and Polypyrrole Decorated with Zinc-Doped Copper Oxide Microparticles. Polymers 2020, 12, 1286. [Google Scholar] [CrossRef] [PubMed]
- Harikumar, P.S. Antibacterial Activity of Copper Nanoparticles and Copper Nanocomposites against Escherichia coli Bacteria. Int. J. Sci. 2016, 2, 83–90. [Google Scholar] [CrossRef]
- Ren, E.; Zhang, C.; Li, D.; Pang, X.; Liu, G. Leveraging Metal Oxide Nanoparticles for Bacteria Tracing and Eradicating. VIEW 2020, 1, 20200052. [Google Scholar] [CrossRef]
- Kumar, V.; Prakash, J.; Singh, J.P.; Chae, K.H.; Swart, C.; Ntwaeaborwa, O.M.; Swart, H.C.; Dutta, V. Role of Silver Doping on the Defects Related Photoluminescence and Antibacterial Behaviour of Zinc Oxide Nanoparticles. Colloids Surf. B Biointerfaces 2017, 159, 191–199. [Google Scholar] [CrossRef] [PubMed]
- Prakash, J.; Samriti; Kumar, A.; Dai, H.; Janegitz, B.C.; Krishnan, V.; Swart, H.C.; Sun, S. Novel Rare Earth Metal–Doped One-Dimensional TiO2 Nanostructures: Fundamentals and Multifunctional Applications. Mater. Today Sustain. 2021, 13, 100066. [Google Scholar] [CrossRef]
- Iseppi, R.; Tardugno, R.; Brighenti, V.; Benvenuti, S.; Sabia, C.; Pellati, F.; Messi, P. Phytochemical Composition and In Vitro Antimicrobial Activity of Essential Oils from the Lamiaceae Family against Streptococcus agalactiae and Candida albicans Biofilms. Antibiotics 2020, 9, 592. [Google Scholar] [CrossRef]
- Bomila, R.; Srinivasan, S.; Venkatesan, A.; Bharath, B.; Perinbam, K. Structural, Optical and Antibacterial Activity Studies of Ce-Doped ZnO Nanoparticles Prepared by Wet-Chemical Method. Mater. Res. Innov. 2018, 22, 379–386. [Google Scholar] [CrossRef]
- Vasireddy, L.; Bingle, L.E.H.; Davies, M.S. Antimicrobial Activity of Essential Oils against Multidrug-Resistant Clinical Isolates of the Burkholderia cepacia Complex. PLoS ONE 2018, 13, e0201835. [Google Scholar] [CrossRef]






| Peaks Color | Wavelength (nm) | ||||
|---|---|---|---|---|---|
| x = 0.000 | x = 0.005 | x = 0.010 | x = 0.015 | x = 0.020 | |
| UV | 310 | 310 | 311 | 309 | 309 |
| Violet | 392 | 390 | 392 | 391 | 392 |
| Blue | 457 | 458 | 447 | 455 | 457 |
| Green | 536 | 536 | 536 | 536 | 536 |
| Red | 633 | 628 | 631 | 629 | 623 |
| Bacterial Isolates | MICs and MBCs (mg/mL) | ||||||||||||||
|---|---|---|---|---|---|---|---|---|---|---|---|---|---|---|---|
| x = 0.000 | x = 0.005 | x = 0.010 | x = 0.015 | x = 0.020 | |||||||||||
| MIC | MBC | MIC | MBC | MIC | MBC | MIC | MBC | MIC | MBC | ||||||
| Gram-positive bacteria | |||||||||||||||
| S. aureus | 1.5 | 3 | 2 | 1.5 | 3 | 2 | 1.5 | 3 | 2 | 3 | ˃3 | nd | 1.5 | 3 | 2 |
| E. faecium | 0.375 | 0.75 | 2 | 1.5 | 3 | 2 | 1.5 | 3 | 2 | 1.5 | 3 | 2 | 1.5 | 3 | 2 |
| Gram-negative bacteria | |||||||||||||||
| E. coli | 3 | ˃3 | nd | 3 | ˃3 | nd | 3 | ˃3 | nd | 3 | ˃3 | nd | 3 | ˃3 | nd |
| S. maltophilia | 3 | ˃3 | nd | 1.5 | 3 | 2 | 1.5 | 3 | 2 | 1.5 | 3 | 2 | 3 | ˃3 | nd |
| Nanoparticles | Bacterial Isolates | ||||
|---|---|---|---|---|---|
| Gram-Positive Bacteria | Gram-Negative Bacteria | ||||
| S. aureus | E. faecium | E. coli | S. maltophilia | ||
| Sample | Concentration (mg/mL) | ZOI ± SEM (mm) | |||
| x = 0.000 | 0.1875 | 7 ± 0.0 | 7.6 ± 0.2 | 0 ± 0.0 | 0 ± 0.0 |
| 0.375 | 7 ± 0.0 | 8.6 ± 0.2 | 0 ± 0.0 | 0 ± 0.0 | |
| 0.75 | 7 ± 0.0 | 9 ± 0.7 | 0 ± 0.0 | 0 ± 0.0 | |
| 1.5 | 8 ± 0.4 | 12.3 ± 1.4 | 19 ± 0.9 | 14 ± 0.4 | |
| 3 | 12.3 ± 0.2 | 13.3 ± 0.7 | 22.3 ± 0.3 | 17.3 ± 0.4 | |
| x = 0.005 | 0.1875 | 7 ± 0.0 | 7 ± 0.0 | 0 ± 0.0 | 0 ± 0.0 |
| 0.375 | 7 ± 0.0 | 7 ± 0.0 | 0 ± 0.0 | 0 ± 0.0 | |
| 0.75 | 7 ± 0.0 | 7 ± 0.0 | 10 ± 0.0 | 8.3 ± 0.2 | |
| 1.5 | 9.6 ± 0.2 | 8 ± 0.4 | 15.6 ± 0.7 | 10.6 ± 0.2 | |
| 3 | 13.6 ± 0.2 | 12.3 ± 0.2 | 20 ± 0.4 | 11.6 ± 0.5 | |
| x = 0.010 | 0.1875 | 7 ± 0.0 | 7 ± 0.0 | 0 ± 0.0 | 7 ± 0.0 |
| 0.375 | 7 ± 0.0 | 7 ± 0.0 | 0 ± 0.0 | 7 ± 0.0 | |
| 0.75 | 7.6 ± 0.2 | 7 ± 0.0 | 0 ± 0.0 | 7 ± 0.0 | |
| 1.5 | 7.6 ± 0.2 | 8.6 ± 0.5 | 0 ± 0.0 | 7 ± 0.0 | |
| 3 | 10 ± 0.9 | 10.6 ± 0.7 | 16.6 ± 0.7 | 7 ± 0.0 | |
| x = 0.015 | 0.1875 | 7 ± 0.0 | 7.6 ± 0.2 | 0 ± 0.0 | 0 ± 0.0 |
| 0.375 | 7 ± 0.0 | 7.6 ± 0.2 | 0 ± 0.0 | 0 ± 0.0 | |
| 0.75 | 10.3 ± 0.2 | 7.6 ± 0.2 | 0 ± 0.0 | 0 ± 0.0 | |
| 1.5 | 11.3 ± 0.2 | 7.6 ± 0.2 | 11.6 ± 0.5 | 0 ± 0.0 | |
| 3 | 17.6 ± 1.18 | 7.6 ± 0.2 | 16.3 ± 0.9 | 10.6 ± 0.5 | |
| x = 0.020 | 0.1875 | 0 ± 0.0 | 0 ± 0.0 | 0 ± 0.0 | 0 ± 0.0 |
| 0.375 | 0 ± 0.0 | 0 ± 0.0 | 0 ± 0.0 | 0 ± 0.0 | |
| 0.75 | 0 ± 0.0 | 0 ± 0.0 | 0 ± 0.0 | 0 ± 0.0 | |
| 1.5 | 0 ± 0.0 | 0 ± 0.0 | 0 ± 0.0 | 0 ± 0.0 | |
| 3 | 9.6 ± 0.7 | 9.3 ± 0.5 | 13.6 ± 0.7 | 7.6 ± 0.2 | |
| Dox | 0.25 | 33.6 ± 0.7 | 19.3 ± 0.7 | 27.6 ± 0.2 | 34.6 ± 0.2 |
| Amo | 0.25 | 0 ± 0.0 | 0 ± 0.0 | 0 ± 0.0 | 0 ± 0.0 |
Disclaimer/Publisher’s Note: The statements, opinions and data contained in all publications are solely those of the individual author(s) and contributor(s) and not of MDPI and/or the editor(s). MDPI and/or the editor(s) disclaim responsibility for any injury to people or property resulting from any ideas, methods, instructions or products referred to in the content. |
© 2022 by the authors. Licensee MDPI, Basel, Switzerland. This article is an open access article distributed under the terms and conditions of the Creative Commons Attribution (CC BY) license (https://creativecommons.org/licenses/by/4.0/).
Share and Cite
Adnan, R.M.; Mezher, M.; Abdallah, A.M.; Awad, R.; Khalil, M.I. Synthesis, Characterization, and Antibacterial Activity of Mg-Doped CuO Nanoparticles. Molecules 2023, 28, 103. https://doi.org/10.3390/molecules28010103
Adnan RM, Mezher M, Abdallah AM, Awad R, Khalil MI. Synthesis, Characterization, and Antibacterial Activity of Mg-Doped CuO Nanoparticles. Molecules. 2023; 28(1):103. https://doi.org/10.3390/molecules28010103
Chicago/Turabian StyleAdnan, Russul M., Malak Mezher, Alaa M. Abdallah, Ramadan Awad, and Mahmoud I. Khalil. 2023. "Synthesis, Characterization, and Antibacterial Activity of Mg-Doped CuO Nanoparticles" Molecules 28, no. 1: 103. https://doi.org/10.3390/molecules28010103
APA StyleAdnan, R. M., Mezher, M., Abdallah, A. M., Awad, R., & Khalil, M. I. (2023). Synthesis, Characterization, and Antibacterial Activity of Mg-Doped CuO Nanoparticles. Molecules, 28(1), 103. https://doi.org/10.3390/molecules28010103

